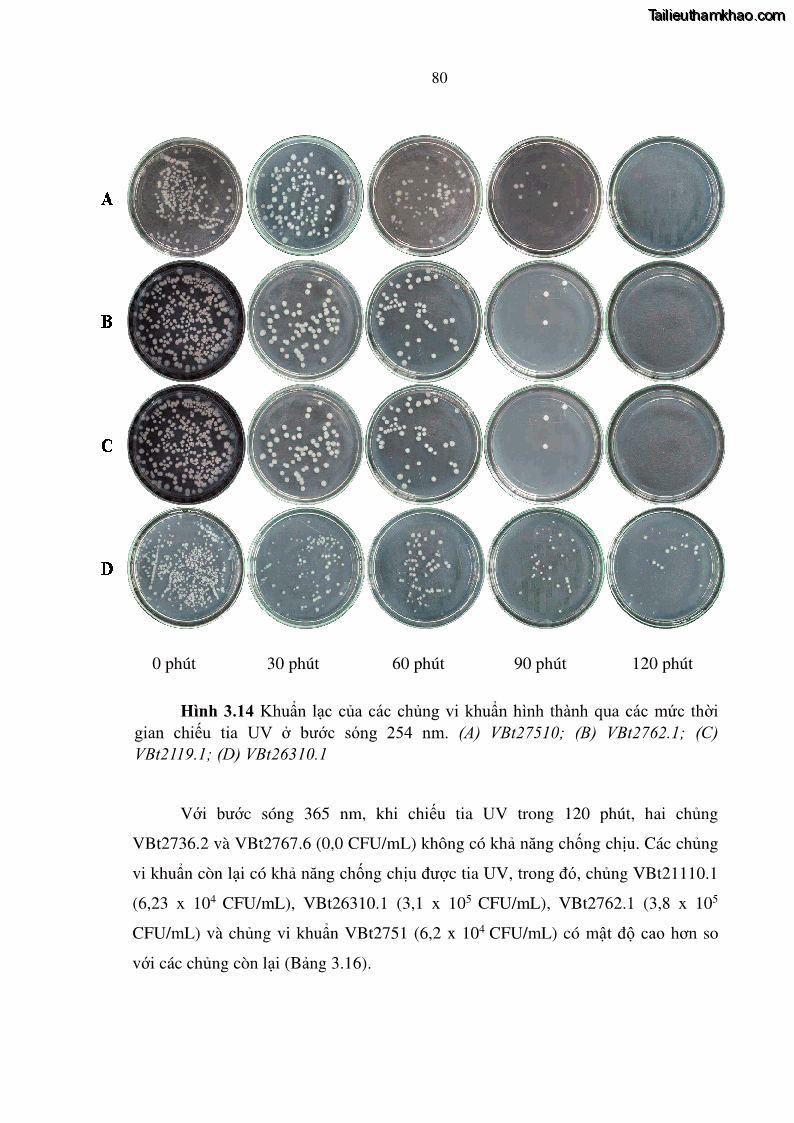
Luận án tiến sĩ bảo vệ thực vật Nghiên cứu sự đa dạng và độc tính của vi khuẩn Bacillus thuringiensis var. kurstaki trên sâu ăn lá hại rau ở Việt Nam - 9 Trang 106
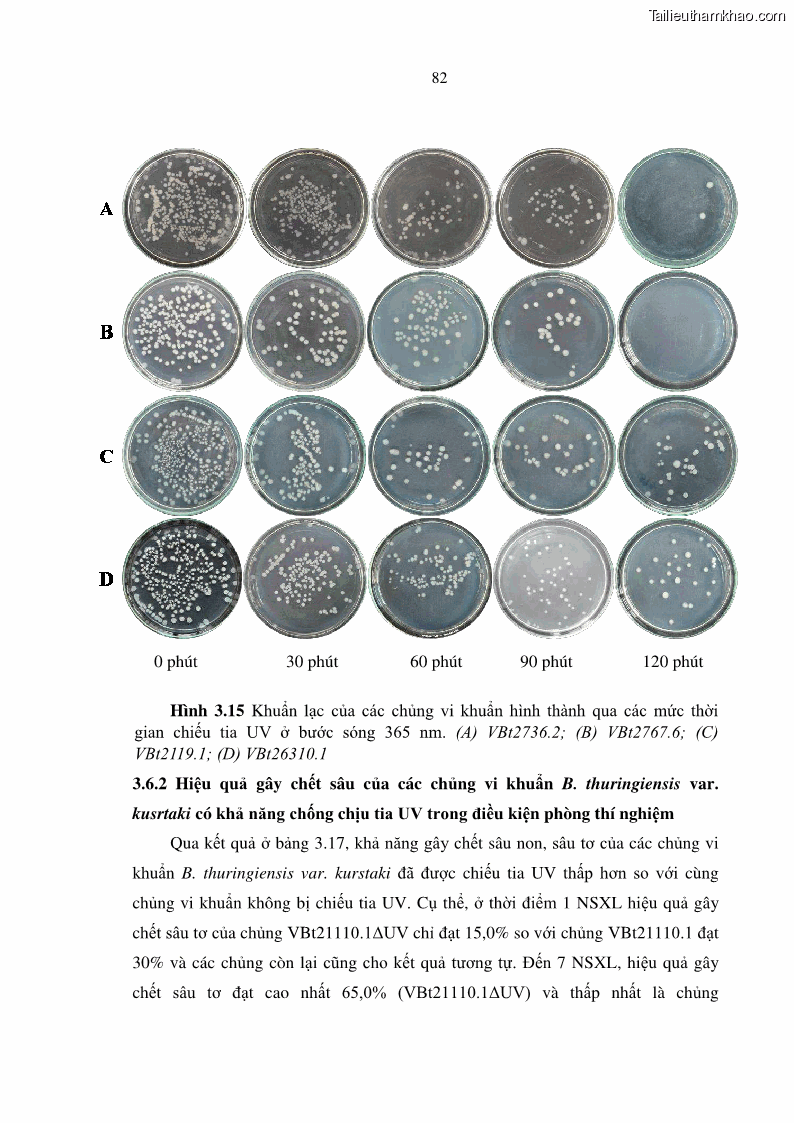
Luận án tiến sĩ bảo vệ thực vật Nghiên cứu sự đa dạng và độc tính của vi khuẩn Bacillus thuringiensis var. kurstaki trên sâu ăn lá hại rau ở Việt Nam - 9 Trang 108

Luận án tiến sĩ bảo vệ thực vật Nghiên cứu sự đa dạng và độc tính của vi khuẩn Bacillus thuringiensis var. kurstaki trên sâu ăn lá hại rau ở Việt Nam - 9 Trang 97
Có thể bạn quan tâm!
-
Luận án tiến sĩ bảo vệ thực vật Nghiên cứu sự đa dạng và độc tính của vi khuẩn Bacillus thuringiensis var. kurstaki trên sâu ăn lá hại rau ở Việt Nam - 6 -
Luận án tiến sĩ bảo vệ thực vật Nghiên cứu sự đa dạng và độc tính của vi khuẩn Bacillus thuringiensis var. kurstaki trên sâu ăn lá hại rau ở Việt Nam - 7 -
Luận án tiến sĩ bảo vệ thực vật Nghiên cứu sự đa dạng và độc tính của vi khuẩn Bacillus thuringiensis var. kurstaki trên sâu ăn lá hại rau ở Việt Nam - 8 -
Luận án tiến sĩ bảo vệ thực vật Nghiên cứu sự đa dạng và độc tính của vi khuẩn Bacillus thuringiensis var. kurstaki trên sâu ăn lá hại rau ở Việt Nam - 10 -
Luận án tiến sĩ bảo vệ thực vật Nghiên cứu sự đa dạng và độc tính của vi khuẩn Bacillus thuringiensis var. kurstaki trên sâu ăn lá hại rau ở Việt Nam - 11 -
Luận án tiến sĩ bảo vệ thực vật Nghiên cứu sự đa dạng và độc tính của vi khuẩn Bacillus thuringiensis var. kurstaki trên sâu ăn lá hại rau ở Việt Nam - 12

Trang 98

Trang 99

Trang 100

Trang 101

Trang 102

Trang 103

Trang 104

Trang 105
Trang 106

Trang 107
Trang 108






